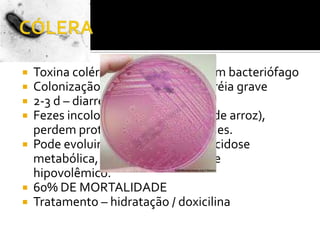
CÓLERAToxina colérica – codificado por um bacteriófagoColonização assintomática à diarréia grave2-3 d – diarréia aquosa e vômitosFezes incolores e inodoras (água de arroz), perdem proteínas e ficam mucóides.Pode evoluir para desidratação, acidose metabólica, hipocalemiae choque hipovolêmico.60% DE MORTALIDADETratamento – hidratação / doxicilina
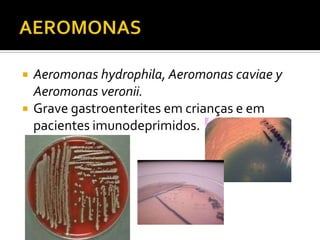
AEROMONASAeromonas hydrophila, Aeromonas caviae y Aeromonas veronii.Grave gastroenterites em crianças e em pacientes imunodeprimidos.

O documento descreve as principais características de espiróquetas, incluindo Treponema pallidum que causa sífilis, Borrelia burgdorferi que causa doença de Lyme, e Leptospira interrogans que causa leptospirose. Também discute víboras como Vibrio cholerae que causa cólera, Campylobacter e Helicobacter pylori associados a doenças gastrointestinais.

![HELICOBACTERGastrite do tipo B (inflamaçãocrônica do antro gástrico [extremo pilórico]).Helicobacterpylori (gastrite), Helicobactercinaedi eHelicobacterfennelliae (gastroenteritis).Gastrite, úlceras pépticas, adenocarcinomagástrico e linfomas de linfocitos B.Espiral bacilar em cultivos recentes, cocos em cultivos antigos.](https://image.slidesharecdn.com/aula8-espiroquetas-110528105204-phpapp01/85/Espiroq-24-320.jpg)






